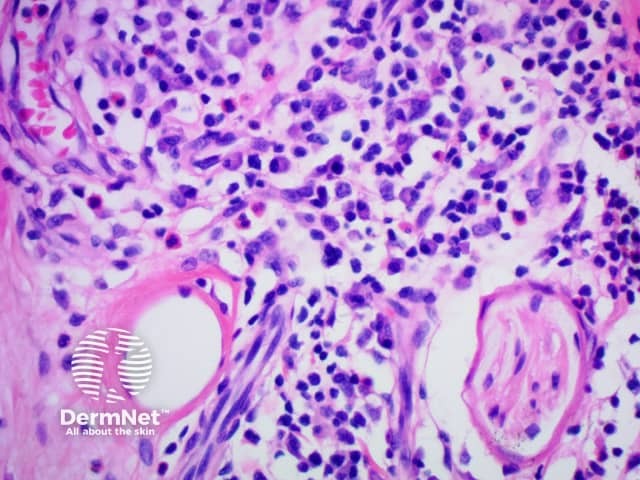

Main menu
Common skin conditions
NEWS
Join DermNet PRO
Read more
Quick links
Author: Dr Priyam Sobarun, Dermatology Registrar, Green Lane Hospital, Auckland, New Zealand. October 2015.
Introduction Histology Special stains Classification Differential diagnoses
IgG4-related disease is a recently described entity. It is characterised by:
Generally, the minimum for making the diagnosis for most tissues is from 30 to 50 IgG4-positive cells per high power field. However, in some organs or tissues e.g kidney, only 10 IgG4-positive plasma cells per high power field may be sufficient.

Figure 1

Figure 2

Figure 5

Figure 6

Figure 7
Yokura et al (2014) proposed a classification of IgG4-related skin disease which divides it into primary, mass-forming lesions due to the direct infiltration of plasma cells and secondary lesions which are due to IgG4-mediated inflammation through secondary mechanisms.
Primary lesions include:
Secondary lesions include:
The diagnostic criteria on histology proposed for skin disease are the following:
Secondary IgG4-related skin disease
The differential diagnosis of immunoglobulin G4-related disease (IgG4-RD) is broad and depends upon the specific site of involvement and clinical presentation.